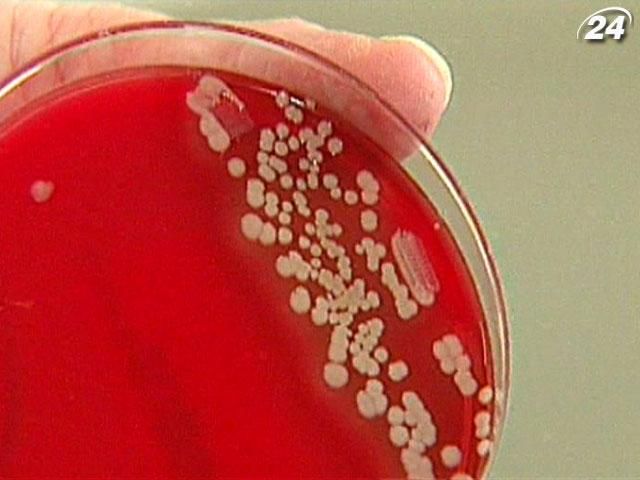
Шпитальні інфекції можуть бути стійкішими за гігієну та антибіотики Шпитальні інфекції можуть бути стійкішими за гігієну та антибіотики

Усі поверхні в операційній мають бути абсолютно стерильними. Фахівець бере мазки з кожного предмета інтер’єру.
Патогени, поширені в лікарні, дуже небезпечні. Те, що їх не вбили ні ретельна гігієна, ні численні антибіотики, вказує на особливу стійкість цих бактерій.
Поширення інфекції може спричинити серйозні недуги, як-от сепсис чи пневмонію. Наслідки будуть непередбачуваними.